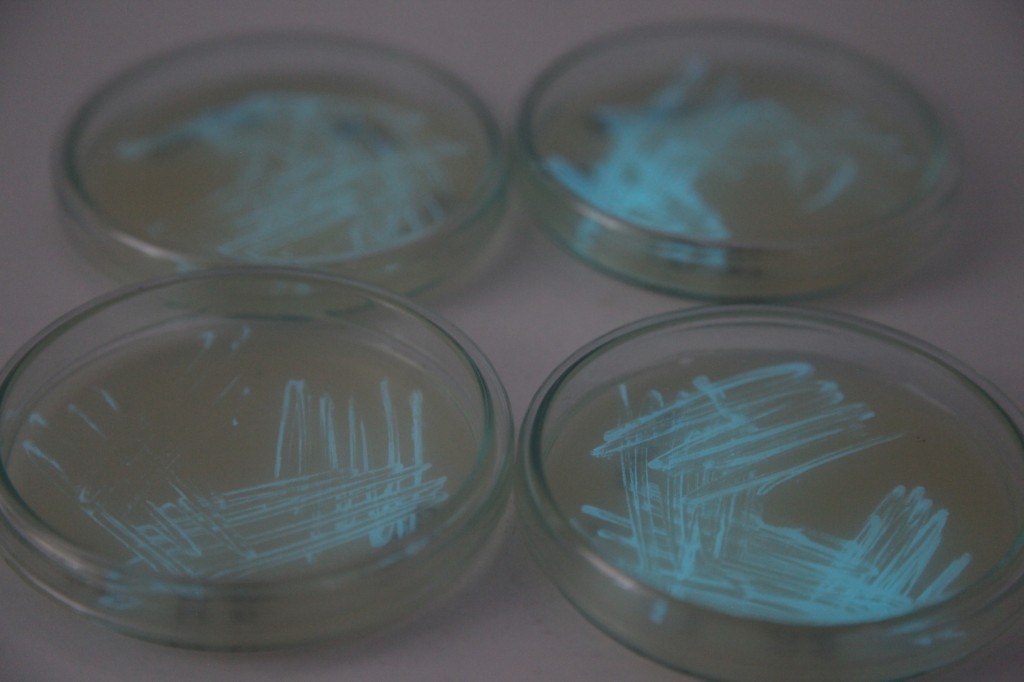
bio.display » Photobacterium Phosphoreum

Photobacterium est un genre de bactéries, représenté par des bacilles mobiles, à coloration de Gram négatif. Chimio-organotrophes, le métabolisme respiratoire est fermentatif. Ces bactéries sont mobiles le plus souvent.
Les espèces du genre Photobacterium sont des bactéries marines, souvent associées aux poissons. Beaucoup d'espèces sont bioluminescentes. Cette bioluminescence est notamment due à une enzyme : la luciférase. Les poissons peuvent héberger les bactéries luminescentes dans un organe particulier. Cette luminescence est utilisée par l'animal lors de divers comportement comme la reproduction, l'attraction de proies ou la dissuasion de prédateurs.
Liste d'espèces
Selon Catalogue of Life (12 avril 2020) et ITIS (12 avril 2020) :
Selon NCBI (12 avril 2020) :
Selon World Register of Marine Species (12 avril 2020) :
- Photobacterium angustum Reichelt, Baumann & Baumann, 1976
- Photobacterium aplysiae Seo, Bae, Yang, Lee & Kim, 2005
- Photobacterium aquimaris Yoshizawa, Wada, Kita-Tsukamoto, Yokota & Kogure, 2009
- Photobacterium damsela Love, Teebken-Fisher, Hose, Farmer III, Hickman & Fanning, 1981
- Photobacterium fischeri (Beijerinck, 1889) Reichelt & Baumann, 1973
- Photobacterium frigidiphilum Seo, Bae, Lee & Kim, 2005
- Photobacterium ganghwense Park, Baik, Seong, Bae, Kim & Chun, 2006
- Photobacterium iliopiscarium Onarheim, Wiik, Burghardt & Stackebrandt, 1994
- Photobacterium indicum Johnson & Weisrock, 1969
- Photobacterium jeanii Chimetto, Cleenwerck, Thompson, Brocchi, Willems, de Vos & Thompson, 2010
- Photobacterium kishitanii Ast, Cleenwerck, Engelbeen, Urbanczyk, Thompson, De Vos & Dunlap, 2007
- Photobacterium leiognathi Boisvert, Chatelain & Bassot, 1967
- Photobacterium lipolyticum Yoon, Lee, Kim & Oh, 2005
- Photobacterium logei (ex Bang, Baumann & Nealson, 1978) Harwood, Bang, Baumann & Nealson, 1980
- Photobacterium lutimaris Jung, Jung, Oh & Yoon, 2007
- Photobacterium profundum Nogi, Masui & Kato, 1998
- Photobacterium rosenbergii Thompson, Thompson, Naser, Hoste, Vandemeulebroecke, Munn, Bourne & Swings, 2005
Notes et références
Références taxinomiques
- (en) BioLib : Photobacterium Beijerinck, 1889 (consulté le )
- (en) Catalogue of Life : Photobacterium Beijerinck, 1889 (consulté le )
- (fr en) EOL : Photobacterium (consulté le )
- (fr en) GBIF : Photobacterium Beijerinck, 1889 (consulté le )
- (en) IRMNG : Photobacterium Beijerinck, 1889 (consulté le )
- (fr en) ITIS : Photobacterium Beijerinck, 1889 (consulté le )
- (en) NCBI : Photobacterium "Photobacter" Beijerinck 1900 (taxons inclus) (consulté le )
- (en) WoRMS : Photobacterium Beijerinck, 1889 ( liste espèces) (consulté le )
Liens externes
- (fr) Photobacterium sur le dictionnaire de bactériologie vétérinaire
- Portail de la microbiologie